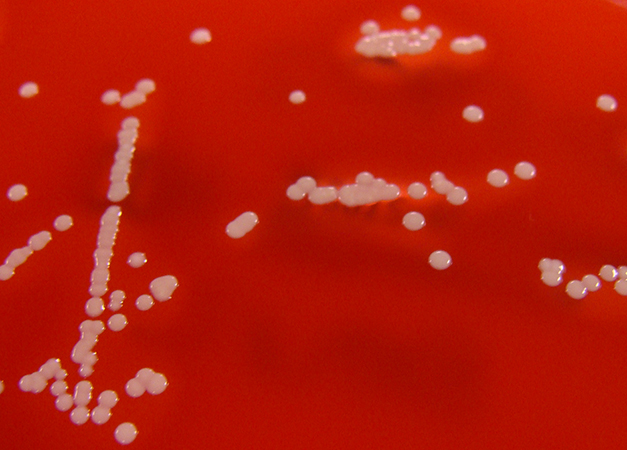

Гемолитический стафилококк принадлежит к семейству микрококковых (лат. Micrococcaceae), виду стафилококков (лат. Staphylococcus). Это микроорганизмы, которые могут вызывать заболевания при определенных условиях. Условно-патогенные микробы получили свое название из-за того, что не всегда вызывают заболевания. Инфекционное заболевание, вызванное стафилококками, развивается у людей с ослабленным иммунитетом.
Среда обитания
Гемолитический стафилококк обитает в организме человека (как у больных, так и у носителей), а также может находиться во внешней среде – на продуктах питания, животных и предметах быта. Бактерии стафилококка могут быть обнаружены на коже, волосах, в носоглотке и в зеве человека. Они обладают устойчивостью к воздействию внешней среды, хорошо переносят изменения температуры и могут находиться в больших количествах в почве и пыли. Токсины стафилококка сохраняют свою активность при температуре до 900С.
Что снижает иммунитет
- Грипп и ОРВИ (нельзя заразиться вирусными инфекциями через ноги)
- Хронические заболевания желудочно-кишечного тракта, печени, поджелудочной железы, почек, сердечно-сосудистой системы
- Расстройства обмена веществ – ожирение, сахарный диабет, заболевания щитовидной железы и прочие
- Курение, злоупотребление алкоголем, хронический стресс, малоподвижный образ жизни, сезонный дефицит витаминов
Источники гемолитического стафилококка и симптомы заболеваний
- Человек сам по себе может стать источником гемолитического стафилококка. Микроорганизмы обитают на коже, поэтому в первую очередь поражают кожу – появляются высыпания, место воспаления краснеет, образуются гнойники, при распространении воспаления на подкожную жировую клетчатку развивается фурункул (воспаление волосяной луковицы), фурункулез (множество фурункулов). При неблагоприятном развитии и несвоевременном лечении фурункул переходит в карбункул (в воспаление вовлекаются несколько волосяных луковиц), возможен абсцесс. Процесс сопровождается плохим самочувствием и подъемом температуры до 380С и выше. Осложнение – заражение крови (сепсис). У лиц, перенесших грипп или ОРВИ, возможны осложнения: стафилококковые бронхиты, пневмонии, гаймориты, гломерулонефриты и другие заболевания.
- Зараженный человек. Пути передачи – воздушно-капельный и контактно-бытовой. При фарингитах, ларингитах, трахеитах гемолитический стафилококк с капельками слюны при кашле и разговоре попадает во внешнюю среду (воздух, предметы обихода, руки) и к здоровому человеку. Появляются слабость, боль в горле, охриплость голоса, кашель. Поэтому лицам с болезнями верхних дыхательных путей рекомендовано носить марлевые повязки. Возможно заражение гемолитическим стафилококком при медицинских, стоматологических, косметологических манипуляциях, которые проводятся нестерильными инструментами.
- Носитель — человек, который здоров, но в его носоглотке есть гемолитический стафилококк. Носителю микроорганизм не приносит вреда, а при попадании к другому человеку вызывает болезнь. Особенно это опасно для новорожденного, так как его иммунитет несовершенен. Поэтому работники детских отделений больниц, родильных домов и детских молочных кухонь проходят профилактические обследования носоглотки. Носителями могут быть здоровые родители. Выяснить это можно после исследования мазка из зева и носа.
- Готовое блюдо или сырой продукт. Гемолитический стафилококк любит температуру, близкую к температуре человеческого тела и питается продуктами, близкими к рациону человека. Размножение гемолитического стафилококка и выделение им токсина происходит при хранении продуктов питания вне холодильника. Размножается и выделяет токсины стафилококк в сырых продуктах (мясе, молоке) и готовых блюдах (мясных, молочных, кондитерских, рыбных, гарнирах и т.д.). В течение 1-2 часов после употребления зараженного продукта появляются тошнота, рвота, поднимается температура до 380С.
Диагностика, лечение, степень опасности
Доктор устанавливает диагноз, но определить, какой микроорганизм вызвал болезнь, можно в специализированных бактериологических лабораториях лечебного учреждения или Центра Гигиены и Эпидемиологии. Для этого биоматериал от пациента (мокрота, раневой экссудат, моча) собирается в стерильную емкость и в течение двух часов после взятия образца доставляется в лабораторию (чтобы микроорганизмы не потеряли свою активность).
Выполняется засев на питательные среды. Микробы разводятся в термостатах при 370С, определяется вид и проверяется чувствительность к антибиотикам. Для этого культура гемолитического стафилококка размещается на чашке Петри, а сверху располагаются диски антибиотиков. Если антибиотик оказывает губительное воздействие, вокруг диска образуется зона отсутствия роста микроорганизма. Чем шире зона отсутствия роста, тем эффективнее работает антибиотик! Именно его выбирают для лечения. Исследование продолжается до 7 суток.
В случае невозможности проведения теста на чувствительность гемолитического стафилококка к антибиотикам (необходимо немедленно начинать лечение), врач принимает решение об использовании антибиотика, который охватывает широкий спектр возможных возбудителей. Сюда относятся цефалоспорины, фторхинолоны, пенициллины и другие препараты.
Оценку степени опасности заболевания для пациента проводит врач, учитывая состояние его иммунитета, стадию заболевания, его местоположение и тяжесть течения. В случае наличия у пациента фурункула, хирург осуществляет вскрытие и дренирование, а также назначает соответствующие антибиотики.
При воспалении горла и слизистой оболочки глотки, помимо применения антибиотиков, рекомендуется использовать препараты от кашля, проводить физиотерапевтические процедуры. При воспалении бронхов и легких – следует принимать препараты, способствующие отхаркиванию, а также употреблять витамины.
При развитии тяжелой формы пневмонии пациента переводят в специализированное отделение больницы и начинают проведение дезинтоксикационной терапии.
Стационарно лечат сепсис, гломерулонефрит, менингит. Обязательно назначают средства для поддержки иммунитета. Применяют стафилококковые иммуноглобулины (готовые антитела к стафилококку), гипериммунную плазму, аутогемотерапию, поливитамины.
Для борьбы с инфекциями, вызванными стафилококками, часто используют бактериофаг. Этот вирус специально нападает на клетки стафилококка и часто применяется в виде компрессов.
Применение средств народной медицины рекомендуется как дополнительное лечение при согласовании с врачом.
Профилактика
Основное внимание следует уделить заботе о собственном здоровье и укреплении иммунитета. При заболеваниях ОРВИ или гриппом необходимо проводить лечение тщательно, предпочтительно в режиме покоя, чтобы избежать осложнений. В случае возникновения осложнений, рекомендуется обратиться к врачу для проведения обследования и назначения соответствующего лечения.
При длительных заболеваниях (например, желудочно-кишечного тракта, печени, почек, поджелудочной железы) следуйте предписанному распорядку дня и принимайте лекарства вовремя.
Если у вас есть проблемы с обменом веществ (например, сахарный диабет, заболевания щитовидной железы или других желез), важно регулярно навещать эндокринолога.
При посещении медицинских учреждений, стоматологических клиник и салонов красоты, следите за тем, какой оборудованием пользуется специалист. Оно должно быть абсолютно чистым и находиться в индивидуальной упаковке.
Избегайте постоянного стресса, уделите больше времени физическим упражнениям и прогулкам на свежем воздухе. Соблюдайте режим работы и отдыха. Обеспечьте себе не менее 7-8 часов сна ежедневно. Здоровое питание поможет укрепить организм и улучшить иммунитет.
Частые вопросы
Что такое гемолитический стафилококк?
Гемолитический стафилококк — это бактерия Staphylococcus aureus, способная разрушать эритроциты и вызывать гемолиз (разрушение красных кровяных клеток).
Каковы причины возникновения инфекции гемолитическим стафилококком?
Инфекция гемолитическим стафилококком может возникнуть при контакте с зараженными поверхностями, через раны или порезы, а также через зараженные продукты питания.
Какие симптомы и как лечить инфекцию гемолитическим стафилококком?
Симптомы инфекции могут включать в себя кожные высыпания, лихорадку, боль и отечность в месте инфекции. Лечение обычно включает антибиотики и местное лечение пораженной области.
Полезные советы
СОВЕТ №1
Обратитесь к врачу для точного диагноза. Гемолитический стафилококк может проявляться различными симптомами, поэтому только специалист сможет поставить правильный диагноз.
СОВЕТ №2
Следуйте рекомендациям врача относительно лечения. Лечение гемолитического стафилококка может включать прием антибиотиков и другие медикаменты, поэтому важно следовать инструкциям специалиста.
СОВЕТ №3
Соблюдайте меры профилактики, такие как регулярное мытье рук, использование антисептических средств и избегание контакта с потенциально зараженными поверхностями, чтобы предотвратить заражение гемолитическим стафилококком.